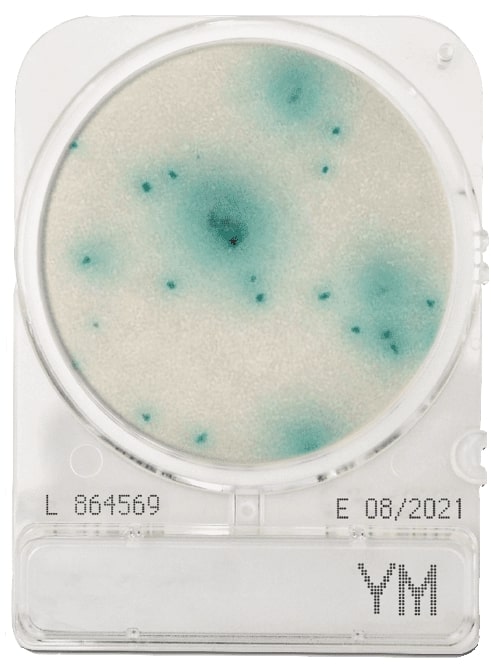
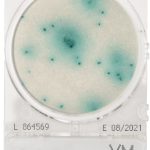

O Compact Dry é um método de ensaio microbiológico simples, seguro e específico, que permite determinar e quantificar microrganismos de alimentos, matérias-primas e ambientais. Possui uma fácil absorção das amostras inoculadas.
Titulador automático Titralab AT1000, 2 buretas, 2 bombas
Preço sob consulta
Funil em vidro, haste curta, ø 150 mm
Preço sob consulta
CompactDry YM (Bolores e Leveduras), cx. 40 placas
66,10€ sem IVA
Marca: CompactDry
Disponível por encomenda a fornecedor
REF:
1000869
Categorias: Em placa, Meios de Cultura
Descrição